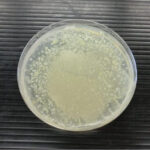

性病検査キットの検査結果が陽性の場合は性病オンライン診療・治療も
性病治療にはクリニックや医療機関に行く必要がありますが、「医療機関に行く時間がない」「クリニックで人と会うのが嫌」「性病科の前で知り合いと会ったらどうしよう」「保険証などで性病治療が家族にバレるのが嫌」といった方もいると思います。そういった方のために、医療機関に行かず、誰にも知られることなく性病治療できるオンライン診療・治療が可能なクリニックを紹介します。初診からオンライン診療が可能ですが、オンライン診療・治療ができるのは、薬で治療できる性病に限られます。